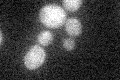
YMR306W
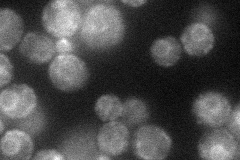
YMR306W
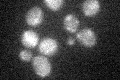
YMR306W

View description
Protein involved in spore wall assembly, has similarity to 1,3-beta-D-glucan synthase catalytic subunits Fks1p and Gsc2p; the authentic, non-tagged protein is detected in highly purified mitochondria in high-throughput studies
Localization:
Intensity:
Fold change:
Significance:
-
C’ GFP library in SD
below threshold16.46 -
N' NOP1pr-GFP in SD
ER38.481 -
N' TEF2pr-mCherry in SD

vacuole18.7103 -
N' NATIVEpr-GFP in SD

below threshold18.546 -
N' TEF2pr-VC and Cyto-VN in SD

#N/A0 -
C’ GFP library in SD+DTT

cytosol15.930.96No -
C’ GFP library in SD+H2O2
cytosol18.031.09No -
C’ GFP library in Starvation Media

cytosol16.461No -
C’ GFP library on the background of Pup2-DaMP

below threshold -
C’ GFP library on the background of CCT mutant

below threshold18.55161.12682No
